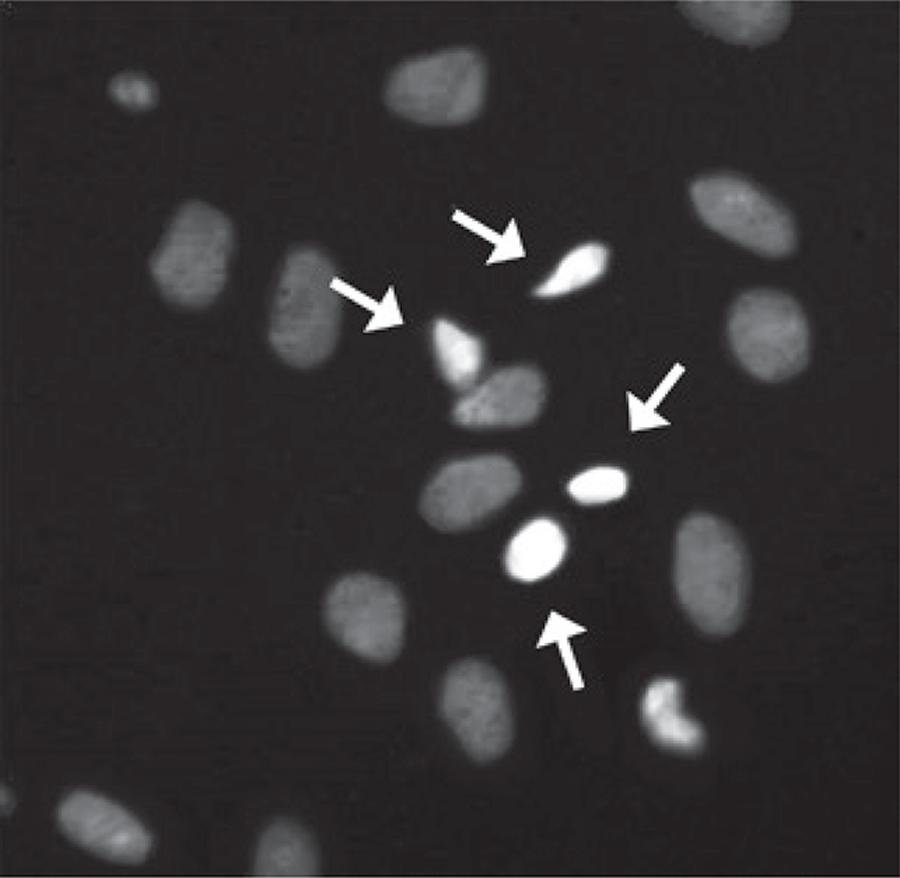

einstein (São Paulo). 01/Jan/2016;14(1):56-63.
Phytochemical analysis of hydroethanolic extract of Turnera diffusa Willd and evaluation of its effects on astrocyte cell death
DOI: 10.1590/S1679-45082016AO3386
ABSTRACT
Objective
To evaluate the phytochemical composition of hydroethanolic extracts from powdered aerial parts of Turnera diffusa Willd (Turneraceae; T. diffusa), as well as its toxicity in astrocytes.
Methods
Chemical analyses of hydroethanolic extract from powdered aerial parts ofT. diffusa were carried out using HPLC-DAD-ESI-MS/MS.In vitro assays using astrocytes culture were performed to evaluate cell death.
Results
Flavone-C, O-diglycosides, such as, luteolin-8-C-[6-deoxy-2-O-rhamnosyl]-xylo-hexos-3-uloside, apigenin-8-C-[6-deoxy-2-O-rhamnosyl]-xylo-hexos-3-uloside and apigenin-7-O-6”-p-coumaroylglucoside were the main compounds found in this hydroethanolic extract. Concentration time-effect demonstrated the toxicity of this extract at a concentration of 1,000µg/mL in astrocyte culture, after 6 and 24 hours of incubation.
Conclusion
In phytochemical analyses, important antioxidants (mainly flavonoids) were observed. T. diffusa extracts presented cytotoxic effect in high concentrations, leading to increased cell death in astrocyte culture.
288